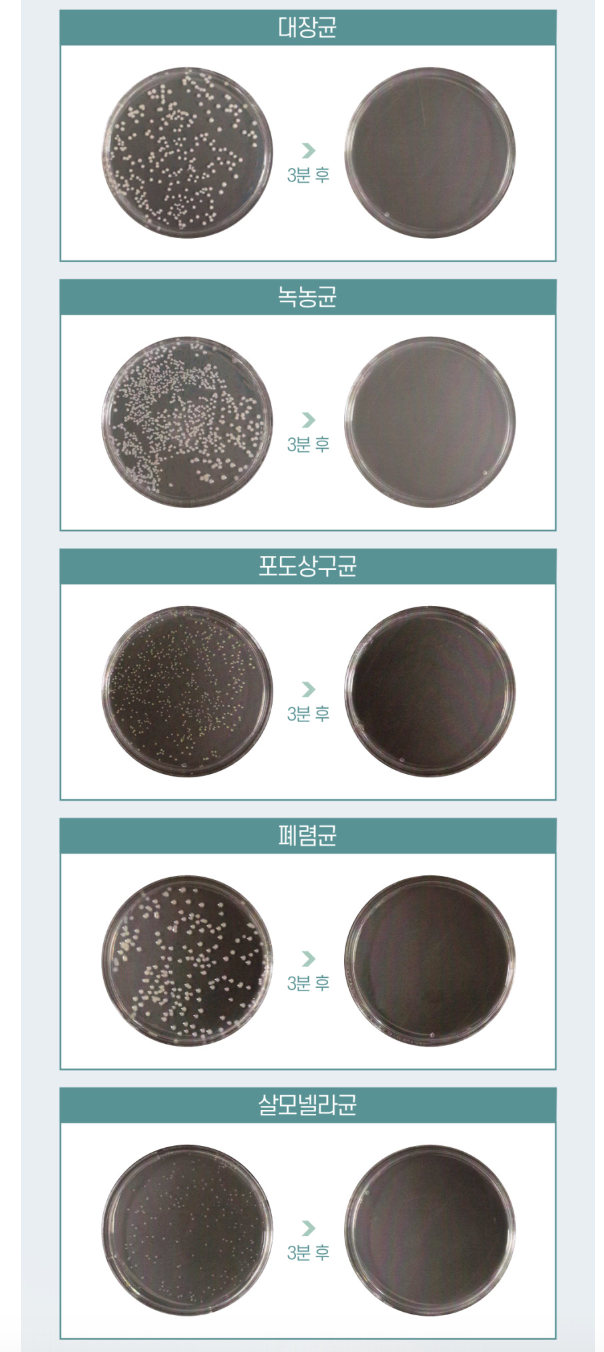

1
/
of
22
Korean Rechargeable Mini Portable UV Toothbrush Sanitizer and Sterilizer Case
Korean Rechargeable Mini Portable UV Toothbrush Sanitizer and Sterilizer Case
Regular price
£29.99 GBP
Regular price
Sale price
£29.99 GBP
Unit price
/
per
Taxes included.
Couldn't load pickup availability
Korean Rechargeable Mini Portable UV Toothbrush Sanitizer and Sterilizer Case
Kills 99.9% of toothbrush bacteria in 3 minutes!
Good points of the Sterilizer Case:
- There is a mirror inside the product to check your teeth, so you don't have to carry a separate mirror.
- It comes with a magnet so you can stick it to the wall.
- It is designed to fit only the toothbrush head, making it easy to carry and take with you when travelling.
- kills 99.9% of E. coli, Pseudomonas aeruginosa, Staphylococcus aureus, Streptococcus pneumoniae, and Salmonella, which are the five major bacteria that cause oral diseases such as cavities, periodontal disease, and gum disease.
- This item is mini-sized, easy to carry, with UVC LED USB charging and magnetic detachable side, killing 99.9% germ sterilization.
Details
-
Power 5V
USB C type charging
UVC LED lifespan: about 20,000 hours -
Size 70 x 51 x 25 mm
Weight 450g - MADE IN KOREA
Share